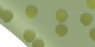

Material Stradegy + Sustainability



My goal in choosing my materials was based on two factors. The general sustainabilty and longevity of the product as well as its aesthetics. Choosing the materials not only because of their contribution to the overall design and narrative of the project, but also in how these materials will improve the buildings carbon emmisions and overall sustainability throughout the buildings life.





Hardwood Flooring

Glulam beams are the largest of the structural members in my project. These custom curved members support the majority of the buildings roof and allow for the main library spaces to be open from floor to ceiling. They are supported by custom glulam columns that are shaped to be structural and provide aesthetics to the project.
: 725 m^3 of lumber


: US and Cananada
ClT panels make up the majority of the walls and floors of the library. Structural 5 PLY panels are used around the e exterior of the building while 3 Ply panels are used in various location within the interior of the spaces.


Grow this ammount in 2
: 625 metric tons of CO2

Total Embodied Energy Total Operating Hours

17,452,105.08 MJ 122,195,174.17 HRS
Glulam columns are used to support the CLT floors where necessary in combination with beams within the interior of the building. They are also used to support the cantilevered facade on the east and western sides of the library.

: Avoided 250 metric tons of carbon emmisions
: 895 metric tons of CO2
: 895 metric tons of CO2
: Operate 94 homes per year
S t ur c t u r e lam CLTpanels + GlulamPlusBeams and C o snmu - Greengaurd Gold Certification for Building Products and Interior finishes - PEFC Certified Raw Material - International KOMO Certification - Nordic Swan Ecolabel - TMT Certification - CE Marked Products - Longterm storage point for CO - Chemical free natural heating and steam process - Sourced so that the forest binds more carbon that emmits throught the harvesting process - Raw Materials Tested by in house Qulaity Control Lab - Testing of new raw materials -Compressive strength tests of concrete products - Batch results monitored by automated bath systems - Contributes to LEED building certifications - Durable - Low maintenance - Long Lasting - Improves air quality within building-UL Certified systemLunawoodThermowoodBattenPanel s DeltaIndustries Concrete Do ickerson TerrazoF n g Ca EPDM RoofingM ane KawneerEnCORE FramingSystem -UL Certified Material - Safety factor against condensation - UV Resistant - Puncture Resistant - Resistance to unwanted biological growth
Glulam Beams Glulam Beams Carbon Calculations V Glulam Columns Glulam Columns CLT Panels CLT Panels Terrazo Flooring Lunawood Panels EnCORE System Concrete Unit Weight : 5 lbs/ft^2 Total Weight : 1,182.00 ft^2 Embodied Energy 260,030.69 MJ Operating Hours : 1,815,380.32 hrs Unit Weight 150 lbs/ft^3 Total Weight : 1,755,000 lbs Embodied Energy : 597,040. 47 MJ Operating Hours 4,146,138.16 hrs Unit Weight 36.00 lbs/ft^3 Total Weight : 149,688 lbs Embodied Energy : 814,767 MJ Operating Hours 5,673,614.04 hrs Unit Weight : 33 lbs/ft^3 Total Weight : 1,440.00 ft^3 Embodied Energy 282,170.51MJ Operating Hours : 1,962,305.01 hrs Unit Weight : 2 lbs/ft^3 Total Weight : 1000 ft^3 Embodied Energy 17,201.84 MJ Operating Hours : 119,457.23 hrs
Unit Weight : 3 lbs/ft^2 Total Weight : 4,522.00 ft^2 Embodied Energy 64,004.42 MJ Operating Hours : 444,475.16 hrs Unit Weight : 10.00 lbs/ft^2 Total Weight 57,950.00 lbs Embodied Energy : 10,515,140.75 MJ Operating Hours : 73,021,810.76 hrs Unit Weight : 33 lbs/ft^3 Total Weight : 20,143.00 lbs Embodied Energy 3,619,347.30 MJ Operating Hours : 25,134,356.23 hrs
Membrane Unit Weight : 2 lbs/ft^2 Total Weight : 30,970.00 lbs Embodied Energy 1,278,379.77 MJ Operating Hours : 8,877,637.26 hrs
EPDM
11















12
Interior Render






















13
Interior Render

















14
Interior Render
Southern Exterior Render









15








16
Trail













02 17
of Tears Memorial Shelby Farms Park / Memphis, TN


















18
TRAIL OF TEARS























TRAVERSED 9 STATES








ALABAM A ARKANSAS GEORGI A ILLINOIS KENTUCKY MISSOUR I NORTH CAROLINA OKLAHOMA TENNESSE E

5 TRIBAL NATIONS







THE TRAIL OF TEARS IS THE RESULT OF THE INDIAN REMOVAL ACT OF THE 1830’S SUPPORTED BY PRESIDENT ANDREW JACKSON. THE FIVE MAJOR NATIVE AMERICAN TRIBES LOACTED IN THE SOUTHEASTERN UNITED STATES EAST OF THE MISSISSIPPI RIVER WERE FORCEFULLY REMOVED AND RELOCATED THOUSANDS OF MILES AWAY TO TERRITORIES IN OKLAHOMA. NATIVE AMERICANS FACED HARSH CONDITIONS, LACK OF WATER AND SUPPLIES AND UNFAMILIAR TERRAIN THAT RESULTED IN THE DEATH OF UP TO 15,000 MEN, WOMEN AND CHILDREN.








WHY MEMPHIS?

















Memphis played a crucial role as a pivotal location along the multiple trails taken during the forced relocation of Indigenous people known as the Trail of Tears. Four out of the five major tribes that were relocated came through Memphis on their route to Oklahoma. Situated at the convergence of land and water routes, Memphis served as a central hub for the relocation of numerous tribes. The primary objective of crossing through Memphis was to traverse the Mississippi River and continue moving westward. It is imperative that we honor and commemorate the lives lost during the tragic “Indian Removal Act” of 1838 and educate not only the residents of Memphis but also the wider U.S. population about the horrendous atrocities that took place in Memphis and throughout the southeastern United States during the Trail of Tears.
During the initial stages of the memorial’s development, the main focus was researching the subject matter of the Trail of Tears and identifying significant locations involved during that time. The research led to the placement of the memorial within Memphis, Tennessee, due to its central location in relation to the Trail of Tears. Furthermore, the design of the memorial is directly related to the research of the Trail of Tears, incorporating specific elements that hold importance and meaning to those impacted.



N
LEVEL 1 PLAN
SITE SHELBY FARMS PARK
THE FORCED REMOVAL AND RELOCATION IN THE 1830’S OF EASTERN WOODLANDS NATIVE AMERICANS OF THE SOUTHEAST REGION OF THE UNITED STATES TO A NATIVE AMERICAN TERRITORY WEST OF THE MISSISSIPPI RIVER.
CHEROKEE CREEK CHICKASA W CHOCTAW SEMINOLE
SOURCE : NATIONAL PARK SERVIC E 504 5
OF TRAIL BOTH LAND AND WATER CHICKASAW LA KE 19
MILES
MEMORIAL AXONOMETRIC


































































N
SITE PLAN 20
EAST ELEVATION + SECTION


























































The memorial’s internal spaces offer open-air environments, enveloped by a glass ceiling that covers most of the structure. The glass ceiling is supported by sturdy steel columns wrapped in copper, which not only provide crucial structural support but also bear symbolic significance. These columns serve as a poignant representation of the individuals who lost their lives during the Trail of Tears, supporting the struggles and hardships of those who have come after them, ultimately enabling people today to move forward, free from the pain and turmoil of the past.
As visitors navigate through the memorial, they are enveloped by a copper forest created by these very same columns, designed to mirror the natural landscape of the Indigenous people’s ancestral land. Beyond their aesthetic beauty, these structural members have a powerful emotional impact, eliciting specific feelings and reactions, while simultaneously serving as spaces for educational and historical information about the Trail of Tears.
21
The Trail of Tears Memorial embodies an essential element that captures the essence of the indigenous peoples’ history. The Memorial’s design progression is a profound reflection of their journey from a place of belonging and familiarity to one of excruciating pain and suffering, caused by their displacement. As visitors explore the spaces below, emotions are evoked through the use of specific spatial arrangements, blocking of sightlines, and other design elements.



















































The main memorial space’s floor is deliberately situated ten feet below the surrounding ground surface, and the view of the trees and landscape around the memorial is concealed from visitors. This intentional separation from the surrounding landscape is designed to convey the experience of the indigenous peoples who were torn away from their homes and forced to relocate thousands of miles away to an unknown location, leaving behind the land they once thrived in.



WEST ELEVATION + SECTION
22
EAST ELEVATION + SECTION
EAST ELEVATION + SECTION








































23
The southern landscape held great historical significance for Indigenous peoples who thrived off its resources. With this in mind, the design of the memorial was crafted to honor and connect with nature and the environment. Taking the form of a large, bridge-like structure, the memorial serves to unite the two sides of the existing lake, symbolizing the crucial role that the Mississippi River played in the Trail of Tears. As a major transportation route, the river facilitated the relocation of Indigenous peoples from surrounding states and beyond, making the crossing a significant milestone in their journey westward. The bridge form of the memorial not only symbolizes this momentous crossing, but also serves as a means of connecting visitors to the surrounding landscape, creating a powerful and immersive experience.

24


















MEMORIAL INTERIOR 25
MAIN MEMORIAL INTERIOR


















MAIN PAVILION 26
MEMORIAL INTERIOR
03


Retail Developement + Parking
Downtown Starkville, Mississippi
27







28
LEVEL 1 PLAN
The main objective of this group project was to create a precast concrete parking garage that featured retail spaces at the base of the structure. The first level of the garage consists of a single level of parking, which occupies half of the total allowable building area. The remaining half of the building area was allocated to retail and public spaces intended for the use of residents and visitors of Downtown Starkville, Mississippi.
The commercial spaces include one restaurant and two smaller retail spaces, with public areas interspersed between them. A custom-designed corrugated precast concrete screen ceiling covers the commercial areas, which was created using Rhino software and replicated throughout the entire structure. The restaurant area includes outdoor dining, which is separated from the green space and outdoor seating by a covered area.
The first-floor level’s final feature is a large sculptural ramp that connects the commercial spaces to the main entrance of the Cadence Bank, the intended recipient of the garage.
UP UP 1111 76 SCALE: PROJECT NUMBER: DATE: DRAWN/MODELED BY: PROJECT 5 ALEXIS GREGORY MOHSEN GARSHASBY RYAN ASHFORD BRIAR JONES HANS HERRMANN TEAM 10 HAYDEN HERRON MADDOX HAZEL MIC WILKINS TREY JACKSON SPENCER LAND INSTRUCTORS HAYDEN HERRON MADDOX HAZEL MIC WILKINS TREY JACKSON SPENCER LAND 1/8" = 1'-0" Z106 Team10-Level 1 5.1 MARCH 25, 2021 NO DESC DATE 1/8" = 1'-0" A -Garage Level 1
29
UP DN Z113SCALE: PROJECT NUMBER: DATE: DRAWN/MODELED BY: PROJECT 5 ALEXIS GREGORY MOHSEN GARSHASBY RYAN ASHFORD BRIAR JONES HANS HERRMANN TEAM 10 HAYDEN HERRON MADDOX HAZEL MIC WILKINS TREY JACKSON SPENCER LAND INSTRUCTORS HAYDEN HERRON MADDOX HAZEL MIC WILKINS TREY JACKSON SPENCER LAND 1/8" = 1'-0" Z103 Team10-Level 3 5.1 MARCH 25, 2021 O SC 1/8" = 1'-0" Z103 A -Garage Level 3 DN 1 Z113 1 Z112SCALE: PROJECT NUMBER: DATE: DRAWN/MODELED BY: PROJECT 5 ALEXIS GREGORY MOHSEN GARSHASBY RYAN ASHFORD BRIAR JONES HANS HERRMANN TEAM 10 HAYDEN HERRON MADDOX HAZEL MIC WILKINS TREY JACKSON SPENCER LAND INSTRUCTORS HAYDEN HERRON MADDOX HAZEL MIC WILKINS TREY JACKSON SPENCER LAND 1/8" = 1'-0" Z105 Team10-Level 5 5.1 MARCH 25, 2021 NO DESC DATE 1/8" = 1'-0" A -Garage Level 5
5 PLAN 30
LEVEL 3 PLAN LEVEL
Creating heavily designed facades for the garage was a crucial aspect of the project’s design intent. To achieve this, not only were the main exterior facades of the garage embellished with precast panels, but all sides were adorned to ensure uniformity and consistency, as seen from the west elevation of the parking garage. The southern facade, in particular, features precast panels, which are complemented by a visually striking egress staircase situated at the southwestern corner of the building. The incorporation of the staircase into the design of the southern facade served not only to meet code requirements for egress but also to break up the monotony of the precast panels, resulting in a more captivating and alluring appearance for passersby in the area.


































































































































































-- Garage Level---1 Z113 - Garage RoofSCALE: PROJECT NUMBER: DATE: MODELED/DRAWN BY: PROJECT 5.0 ALEXIS GREGORY MOHSEN GARSHASBY RYAN ASHFORD BRIAR JONES HANS HERRMANN TEAM 10 MIC WILKINS MADDOX HAZEL TREY JACKSON SPENCER LAND HAYDEN HERRON INSTRUCTORS MIC WILKINS MADDOX HAZEL TREY JACKSON SPENCER LAND HAYDEN HERRON 1/8" = 1'-0" Z107 N. ELEVATION 5.1 16 APRIL, 2021 1/8" = 1'-0" N. ELEVATION No.DescriptionDate- Garage Level--- Garage Level1 Z113PROJECT NUMBER: DATE: MODELED/DRAWN BY: PROJECT 5.0 ALEXIS GREGORY MOHSEN GARSHASBY RYAN ASHFORD BRIAR JONES HANS HERRMANN TEAM 10 MIC WILKINS MADDOX HAZEL TREY JACKSON SPENCER LAND HAYDEN HERRON INSTRUCTORS MIC WILKINS MADDOX HAZEL TREY JACKSON SPENCER LAND HAYDEN HERRON Z112 NORTH SECTION 5.1 16 APRIL, 2021 No.DescriptionDate SOUTH ELEVATION SOUTH SECTION 31
NORTH ELEVATION












































































































The northern section of the garage is seamlessly linked with Cadence Bank, creating the principal rear entrance and an ADA-accessible path through the sculptural ramp. This remarkable ramp serves not only as an exit and an accessible way for disabled individuals but also as an extraordinary design feature that enchants and engages every visitor. The creation of this ramp was significant, not just in making it accessible to people with disabilities, but also in sculpting it as an inclusive art form that welcomes all visitors.
This section boasts a garage with a snaking form, achieved through end caps molded from precast panel elements. The resulting shape is repeated throughout the project, at varying scales, to both define space and provide a screen for the garage. The repetitive use of these precast elements not only achieves uniformity in the exterior design but also optimizes efficiency and cost-effectiveness during the manufacturing process. Despite variations in size, the panels are standardized to promote environmental and temporal efficiency.































































-----1 Z113SCALE: PROJECT NUMBER: DATE: MODELED/DRAWN BY: ALEXIS GREGORY MOHSEN GARSHASBY RYAN ASHFORD BRIAR JONES HANS HERRMANN TEAM 10 MIC WILKINS MADDOX HAZEL TREY JACKSON SPENCER LAND HAYDEN HERRON INSTRUCTORS MIC WILKINS MADDOX HAZEL TREY JACKSON SPENCER LAND HAYDEN HERRON 1/8" = 1'-0" Z108 S. ELEVATION 5.1 16 APRIL, 2021 1/8" = 1'-0" S. ELEVATION No.DescriptionDate-- Garage Level-- Garage Roof1 Z112PROJECT NUMBER: DATE: MODELED/DRAWN BY: PROJECT 5.0 ALEXIS GREGORY MOHSEN GARSHASBY RYAN ASHFORD BRIAR JONES HANS HERRMANN TEAM 10 MIC WILKINS MADDOX HAZEL TREY JACKSON SPENCER LAND HAYDEN HERRON INSTRUCTORS MIC WILKINS MADDOX HAZEL TREY JACKSON SPENCER LAND HAYDEN HERRON Z113 WEST SECTION 5.1 16 APRIL, 2021 A -West Section No.DescriptionDate
WEST SECTION
32
WEST ELEVATION
























































































EAST ELEVATION






















































































- Garage Level- Garage Level----1 T113 SCALE: PROJECT NUMBER: DATE: MODELED/DRAWN BY: PROJECT 5.0 ALEXIS GREGORY MOHSEN GARSHASBY RYAN ASHFORD BRIAR JONES HANS HERRMANN TEAM 10 MIC WILKINS MADDOX HAZEL TREY JACKSON SPENCER LAND HAYDEN HERRON INSTRUCTORS MIC WILKINS MADDOX HAZEL TREY JACKSON SPENCER LAND HAYDEN HERRON Z109 E. ELEVATION 5.1 16 APRIL, 2021 1/8" = 1'-0" Z109 E. ELEVATION No.DescriptionDate- Garage Level- Garage Level- Garage Level--1 Z112 1 T113 SCALE: PROJECT NUMBER: DATE: MODELED/DRAWN BY: PROJECT 5.0 ALEXIS GREGORY MOHSEN GARSHASBY RYAN ASHFORD BRIAR JONES HANS HERRMANN TEAM 10 MIC WILKINS MADDOX HAZEL TREY JACKSON SPENCER LAND HAYDEN HERRON INSTRUCTORS MIC WILKINS MADDOX HAZEL TREY JACKSON SPENCER LAND HAYDEN HERRON 1/8" = 1'T108 W. ELEVATION 5.1 16 APRIL, 2021 1/8" = 1'-0" W. ELEVATION No.DescriptionDate
33
An essential aspect of the parking garage’s holistic design was to incorporate an area for visitors to relish the fresh air and surroundings. To achieve this objective, a spacious outdoor zone was crafted, complete with comfortable seating and expansive green areas. This thoughtful addition not only contrasts the sturdy concrete structure of the parking garage but also provides a serene escape for visitors of Cadence Bank, the retail and restaurant establishments, and even nearby inhabitants to unwind and embrace nature’s beauty.






34
5 PLAN
LEVEL


















+ RETAIL FACADE 35
RESTAURANT INTERIOR RESTAURANT


















GARAGE
+
RETAIL INTERIOR COMMON SPACE 36
LOOKOUT
BANK ACCESS RAMP
Connection details and drawings were made to show how the precast panel would be attached to the garage. There were many different types of precast panel connections but only a few worked with our design due to the ammount of open space in our panel. These drawings highlight the materials needed in order to make this connection as well as how the panel is attached. Due to the vertical span of the precast panel there is connections oor of the garage with the panel spanning both of the





Level 1 10' - 0" Leve 2 20' - 0" Level 1 10' - 0" Level 2 20' - 0" Leve 1 10' -0" Leve 2 20' - 0" 1/2" = 1'-0" 1 Elevation 1 -a 1/2" = 1'-0" 2 Elevation 1 -d 1/2" = 1'-0" 3 Elevation 2 -b
37
The sketches present a comprehensive demonstration of the intricate interplay between the precast panels, the parking garage framework, and the floor slabs. The precast concrete panels are expertly crafted with strategically designated spaces for the installation of steel plates post-casting. These steel plates serve as the backbone of the entire structure, connecting the panels and providing a solid, unwavering foundation at various levels throughout the floors. The use of various panel sizes not only fosters the creation of expansive, uninterrupted spaces but also facilitates the seamless extension of the garage’s full height.
Connection details and drawings were made to show how the precast panel would be attached to the garage. There were many different types of precast panel connections but only a few worked with our design due to the ammount of open space in our panel. These drawings highlight the materials needed in order to make this connection as well as how the panel is attached. Due to the vertical span of the precast panel there is connections on each oor of the garage with the panel spanning both of the oors.
Displayed below are miniature replicas produced via 3D printing of the precast modules that were designed and modeled in Rhino. The visuals also depict the evolution of the panel’s design, illustrating how certain sections were thickened and beveled to facilitate the casting process. Concrete was used to cast these panels to scale, highlighting not only the successful casting of the modules, but also demonstrating how the interplay of light and shadow can impact the panel’s surface.






10' - 0" Leve 2- 0" Level 2Leve Elevation -a 2 Elevation 1 -d 3 Elevation 2 -b Level 1 10' - 0" A107 20' - 0" Level 10 - 0" 1" = 1'-0" 1 Section PRECAST PANEL 2" SITECAST (I SLAB) (I PRECAST PANEL) 1/4" STEEL REINFORCING SLAB REINFORCING 12"X8 CONCRETE BEAM TO ENBED ANGLE IRON CONNECTIO 3" = 1'-0" Sectio 1 -C allout 1 3/4" BOLTS B)
PANEL ELEVATIONS 20
PANEL CONNECTION DETAILS
38
THANK YOU


























































































































































































































































































































































































































































































































































































































































































































































































































































































































































































































































































































































